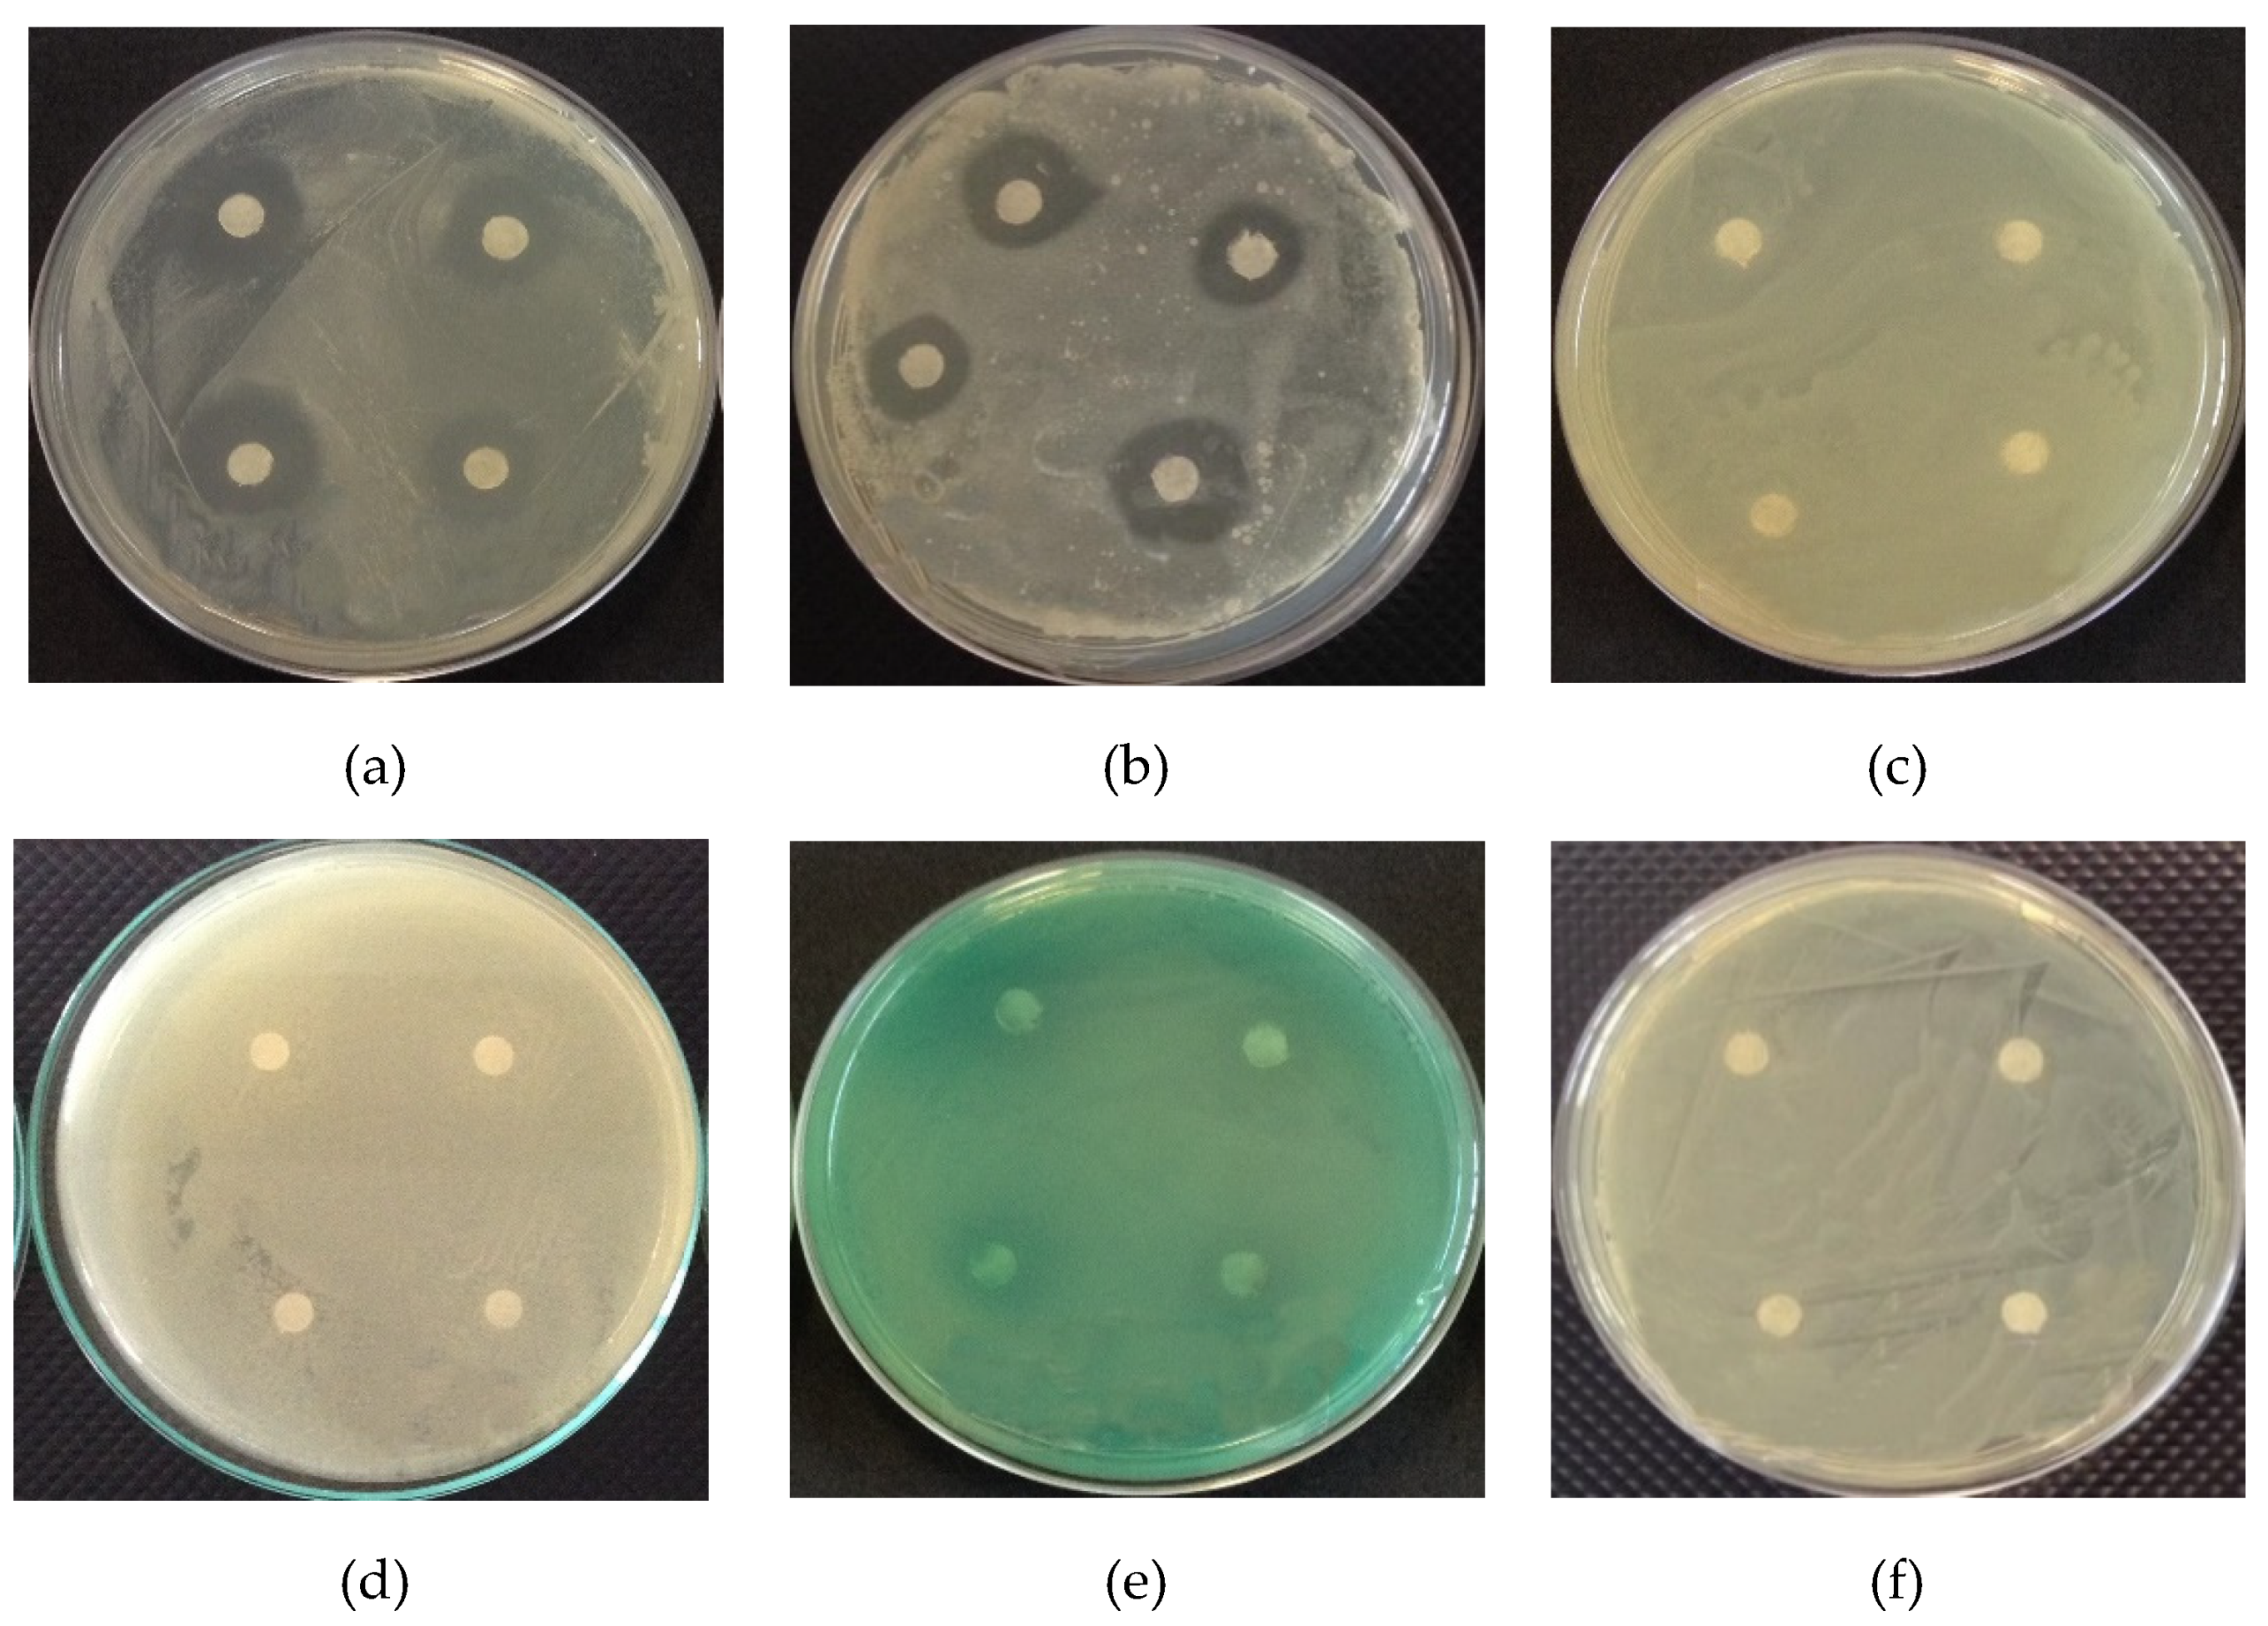
Polymers 12 02883 g001

Antimicrobial Activity and GC-MS Profile of Copaiba Oil for Incorporation into Xanthosoma mafaffa Schott Starch-Based Films
Abstract
:1. Introduction
2. Materials and Methods
2.1. Material
2.2. Methods
2.2.1. Chemical Composition of Copaiba Oil
2.2.2. Zone of Inhibition Test
2.2.3. Minimum Inhibitory Concentration (MIC)
2.3. Production of Microparticles with Copaiba Oil
2.4. Production of Films
2.5. Caracterization of Films
2.5.1. Visual Analysis, Scanning Electron Microscopy, and Atomic Force Microscopy
2.5.2. UV/Visible Barrier, Transparency, and Luminosity
2.5.3. Thickness and Mechanical Properties
2.5.4. Moisture, Solubility in Water, and Contact Angle
2.5.5. Fourier Transform Infrared (FTIR) Spectroscopy
2.5.6. Antimicrobial Activity
2.6. Statistical Analysis
3. Results and Discussion
3.1. Caracterization of Copaiba Oil
3.1.1. Chemical Composition of Copaiba Oil
3.1.2. Zone of Inhibition Test
3.1.3. Minimum Inhibitory Concentration (MIC)
3.2. Caracterization of Films
3.2.1. Visual Analysis, Scanning Electron Microscopy, and Atomic Force Microscopy
3.2.2. UV/Visible Barrier, Transparence, and Luminosity
3.2.3. Thickness and Mechanical Properties
3.2.4. Moisture, Solubility, and Contact Angle
3.2.5. Fourier Transform Infrared (FTIR) Spectroscopy
3.2.6. Antimicrobial Activity
4. Conclusions
Author Contributions
Funding
Conflicts of Interest
References
- Pelissari, F.M.; Ferreira, D.C.; Louzada, L.B.; Dos Santos, F.; Corrêa, A.C.; Moreira, F.K.V.; Mattoso, L.H. Starch-Based Edible Films and Coatings: An Eco-Friendly Alternative for Food Packaging; Elsevier Inc.: Amsterdam, The Netherlands, 2018; ISBN 9780128094402. [Google Scholar]
- Versino, F.; Lopez, O.V.; Garcia, M.A.; Zaritzky, N.E. Starch-based films and food coatings: An overview. Starch/Staerke 2016, 68, 1026–1037. [Google Scholar] [CrossRef]
- Kim, Y.; Yoo, S.-H.; Park, K.-H.; Shim, J.-H.; Lee, S. Functional characterization of native starches through thermal and rheological analysis. J. Korean Soc. Appl. Biol. Chem. 2012, 55, 413–416. [Google Scholar] [CrossRef]
- Guo, K.; Lin, L.; Fan, X.; Zhang, L.; Wei, C. Comparison of structural and functional properties of starches from five fruit kernels. Food Chem. 2018, 257, 75–82. [Google Scholar] [CrossRef] [PubMed]
- Yang, Q.; Zhang, W.; Luo, Y.; Li, J.; Gao, J.; Yang, P.; Gao, X.; Feng, B. Comparison of structural and physicochemical properties of starches from five coarse grains. Food Chem. 2019, 288, 283–290. [Google Scholar] [CrossRef] [PubMed]
- Duan, X.; Han, H.; Deng, R.; Wu, P. Drying treatments on Chinese yam (Dioscorea spp.) prior to wet milling influence starch molecular structures and physicochemical properties. Food Hydrocoll. 2020, 102. [Google Scholar] [CrossRef]
- Nogueira, G.F.; Fakhouri, F.M.; de Oliveira, R.A. Extraction and characterization of arrowroot (Maranta arundinaceae L.) starch and its application in edible films. Carbohydr. Polym. 2018, 186, 64–72. [Google Scholar] [CrossRef] [PubMed]
- Souza Gomes, D.; do Prado Cordoba, L.; Rosa, L.S.; Spier, M.R.; Schnitzler, E.; Waszczynskyj, N. Thermal, pasting properties and morphological characterization of pea starch (Pisum sativum L.), rice starch (Oryza sativa) and arracacha starch (Arracacia xanthorrhiza) blends, established by simplex-centroid design. Thermochim. Acta 2018, 662, 90–99. [Google Scholar] [CrossRef]
- Aschogbon, A.O.; Oluwafemi, A.D. Physicochemical properties of microwaved starch blends from cocoyam (Xanthosoma sagittifolium) and pigeon pea (Cajanus cajan) for industrial applications. J. Chem. 2018, 43, 189–204. [Google Scholar] [CrossRef] [Green Version]
- Ávila, R.; Ascheri, D.P.R.; Ascheri, J.L.R. Caracterização dos rizomas filhos e da fécula do mangarito (Xanthosoma mafaffa Schott) e elaboração de filmes biodegradáveis. Bol. Cent. Pesqui. Process. Aliment. 2012, 30, 35–52. [Google Scholar]
- Zárate, N.A.H.; Vieira, M.D.C.; Pontim, B.C.Á. Arranjo de plantas na produção do mangarito (Xanthosoma mafaffa Schott) ‘Comum’. Acta Sci. Agron. 2005, 27, 409–413. [Google Scholar] [CrossRef] [Green Version]
- Madeira, N.R.; Botrel, N.; Amaro, G.B.; de Castro e Melo, R.A. Mangarito: Sabor de tradição. Hortic. Bras. 2015, 33, 409. [Google Scholar] [CrossRef] [Green Version]
- Jiménez, A.; Fabra, M.J.; Talens, P.; Chiralt, A. Effect of re-crystallization on tensile, optical and water vapour barrier properties of corn starch films containing fatty acids. Food Hydrocoll. 2012, 26, 302–310. [Google Scholar] [CrossRef]
- Atarés, L.; Chiralt, A. Essential oils as additives in biodegradable films and coatings for active food packaging. Trends Food Sci. Technol. 2016, 48, 51–62. [Google Scholar] [CrossRef]
- Leandro, L.M.; De Sousa Vargas, F.; Barbosa, P.C.S.; Neves, J.K.O.; Silva, J.A.; Da Veiga-Junior, V.F. Chemistry and biological activities of terpenoids from copaiba (Copaifera spp.) oleoresins. Molecules 2012, 17, 3866–3889. [Google Scholar] [CrossRef] [PubMed] [Green Version]
- FDA Food and Drug—PART 172 Food Additives Permitted for Direct Addition to Food for Human Consumption. Available online: https://www.accessdata.fda.gov/scripts/cdrh/cfdocs/cfcfr/CFRSearch.cfm?CFRPart=172&showFR=1 (accessed on 30 September 2020).
- Brandelero, R.P.H.; De Almeida, F.M.; Alfaro, A. Microestrutura e propriedades de filmes de amido-álcool polivinílico-alginato adicionados de óleos essenciais de copaíba e capim limão. Quim. Nova 2015, 38, 910–916. [Google Scholar] [CrossRef]
- Morelli, C.L.; Mahrous, M.; Belgacem, M.N.; Branciforti, M.C.; Bretas, R.E.S.; Bras, J. Natural copaiba oil as antibacterial agent for bio-based active packaging. Ind. Crops Prod. 2015, 70, 134–141. [Google Scholar] [CrossRef]
- Song, X.; Zuo, G.; Chen, F. Effect of essential oil and surfactant on the physical and antimicrobial properties of corn and wheat starch films. Int. J. Biol. Macromol. 2018, 107, 1302–1309. [Google Scholar] [CrossRef]
- Avila-Sosa, R.; Palou, E.; Jiménez Munguía, M.T.; Nevárez-Moorillón, G.V.; Navarro Cruz, A.R.; López-Malo, A. Antifungal activity by vapor contact of essential oils added to amaranth, chitosan, or starch edible films. Int. J. Food Microbiol. 2012, 153, 66–72. [Google Scholar] [CrossRef]
- Medeiros, J.A.S.; Blick, A.P.; Galindo, M.V.; Alvim, I.D.; Yamashita, F.; Ueno, C.T.; Shirai, M.A.; Grosso, C.R.F.; Corradini, E.; Sakanaka, L.S. Incorporation of oregano essential oil microcapsules in starch-poly (Butylene Adipate Co-Terephthalate) (PBAT) Films. Macromol. Symp. 2019, 383, 1–7. [Google Scholar] [CrossRef] [Green Version]
- Sánchez-González, L.; González-Martínez, C.; Chiralt, A.; Cháfer, M. Physical and antimicrobial properties of chitosan-tea tree essential oil composite films. J. Food Eng. 2010, 98, 443–452. [Google Scholar] [CrossRef]
- Donsì, F.; Annunziata, M.; Sessa, M.; Ferrari, G. Nanoencapsulation of essential oils to enhance their antimicrobial activity in foods. LWT Food Sci. Technol. 2011, 44, 1908–1914. [Google Scholar] [CrossRef]
- Rutz, J.K.; Borges, C.D.; Zambiazi, R.C.; Crizel-Cardozo, M.M.; Kuck, L.S.; Noreña, C.P.Z. Microencapsulation of palm oil by complex coacervation for application in food systems. Food Chem. 2017, 220, 59–66. [Google Scholar] [CrossRef] [PubMed]
- Adams, R.P. Identification of Essential oil Components by Gas Chromatography/Mass Spectrometry, 8th ed.; Allured Publishing Corporation: Carol Stream, IL, USA, 2007. [Google Scholar]
- NCCLS. Performance Standards for Antimicrobial Disk Susceptibility Tests—M2-A8, 8th ed.; NCCLS: Wayne, PA, USA, 2003. [Google Scholar]
- Mendonça, D.E.; Onofre, S.B. Atividade antimicrobiana do óleo-resina produzido pela copaiba—Copaifera multijuga Hayne (Leguminosae). Braz. J. Pharmacogn. 2009, 19, 577–581. [Google Scholar] [CrossRef] [Green Version]
- Ponce, A.G.; Fritz, R.; Del Valle, C.; Roura, S.I. Antimicrobial activity of essential oils on the native microflora of organic Swiss chard. LWT Food Sci. Technol. 2003, 36, 679–684. [Google Scholar] [CrossRef]
- Palmeira, J.D.; Ferreira, S.B.; Benvindo, S.; Souza, J.H.; Almceida, J.M.; Figueiredo, M.C.; Pequeno, A.S.; Arruda, T.A.; Antunes, R.M.P.; Catão, R.M.R. Avaliação da atividade antimicrobiana in vitro e determinação da concentração inibitória mínima (CIM) de extratos hidroalcóolico de angico sobre cepas de Staphylococcus aureus. Rev. Bras. Análises Clínicas 2010, 42, 33–37. [Google Scholar]
- Alvim, I.D.; Grosso, C.R.F. Microparticles obtained by complex coacervation: Influence of the type ofreticulation and the drying process on the release of the core material. Cienc. Tecnol. Aliment. 2010, 30, 1069–1076. [Google Scholar] [CrossRef] [Green Version]
- Nogueira, G.F.; Fakhouri, F.M.; de Oliveira, R.A. Effect of incorporation of blackberry particles on the physicochemical properties of edible films of arrowroot starch. Dry. Technol. 2019, 37, 448–457. [Google Scholar] [CrossRef]
- Fang, Y.; Tung, M.A.; Britt, I.J.; Yada, S.; Dalgleish, D.G. Tensile and barrier properties of edible films made from whey proteins. J. Food Sci. 2002, 67, 188–193. [Google Scholar] [CrossRef]
- Han, J.H.; Floros, J.D. Casting antimicrobial packaging films and measuring their physical properties and antimicrobial activity. J. Plast. Film Sheeting 1997, 13, 287–298. [Google Scholar] [CrossRef]
- ASTM Standard Test Method for Tensile Properties of Thin Plastic Sheeting; Int. Stand. Method D882-10; ASTM: West Conshohocken, PA, USA, 2010.
- Gontard, N.; Guilbert, S.; Cuq, J.-L. Edible wheat gluten films: Influence of the main process variables on film properties using response surface methodology. J. Food Sci. 1992, 57, 190–195. [Google Scholar] [CrossRef]
- Abdollahi, M.; Damirchi, S.; Shafafi, M.; Rezaei, M.; Ariaii, P. Carboxymethyl cellulose-agar biocomposite film activated with summer savory essential oil as an antimicrobial agent. Int. J. Biol. Macromol. 2019, 126, 561–568. [Google Scholar] [CrossRef] [PubMed]
- Dias, D.D.O.; Colombo, M.; Kelmann, R.G.; Kaiser, S.; Lucca, L.G.; Teixeira, H.F.; Limberger, R.P.; Veiga, V.F.; Koester, L.S. Optimization of copaiba oil-based nanoemulsions obtained by different preparation methods. Ind. Crops Prod. 2014, 59, 154–162. [Google Scholar] [CrossRef]
- Pascoal, D.R.C.; Cabral-Albuquerque, E.C.M.; Velozo, E.S.; de Sousa, H.C.; de Melo, S.A.B.V.; Braga, M.E.M. Copaiba oil-loaded commercial wound dressings using supercritical CO2: A potential alternative topical antileishmanial treatment. J. Supercrit. Fluids 2017, 129, 106–115. [Google Scholar] [CrossRef]
- Barbosa, P.C.S.; Medeiros, R.S.; Sampaio, P.T.B.; Vieira, B.G.; Wiedemann, L.S.M.; Veiga, V.F. Influence of abiotic factors on the chemical composition of copaiba oil (Copaifera multijuga Hayne): Soil composition, seasonality and diameter at breast height. J. Braz. Chem. Soc. 2012, 23, 1823–1833. [Google Scholar] [CrossRef] [Green Version]
- Rodrigues, I.A.; Ramos, A.D.S.; Falcão, D.Q.; Ferreira, J.L.P.; Basso, S.L.; Silva, J.R.D.A.; Amaral, A.C.F. Development of nanoemulsions to enhance the antileishmanial activity of copaifera paupera oleoresins. Biomed Res. Int. 2018, 2018. [Google Scholar] [CrossRef] [PubMed] [Green Version]
- Barbosa, P.C.S.; Wiedemann, L.S.M.; Medeiros, R.S.; Sampaio, P.T.B.; Vieira, G.; Veiga-Junior, V.F. Phytochemical fingerprints of copaiba oils (Copaifera multijuga Hayne) determined by multivariate analysis. Chem. Biodivers. 2013, 10, 1350–1360. [Google Scholar] [CrossRef]
- Herrero-Jáuregui, C.; Casado, M.A.; Das Graças Bichara Zoghbi, M.; Célia Martins-Da-Silva, R. Chemical variability of Copaifera reticulata ducke oleoresin. Chem. Biodivers. 2011, 8, 674–685. [Google Scholar] [CrossRef]
- Emerenciano, D.P.; Baracho, B.B.D.; De Medeiros, M.L.; Rocha, H.A.O.; Xavier, F.H.; Da Veiga, V.F.; Maciel, M.A.M. Physicochemical characterizations and antioxidant property of copaiba oil loaded into SnEDDS systems. J. Braz. Chem. Soc. 2019, 30, 234–246. [Google Scholar] [CrossRef]
- Jamróz, E.; Juszczak, L.; Kucharek, M. Investigation of the physical properties, antioxidant and antimicrobial activity of ternary potato starch-furcellaran-gelatin films incorporated with lavender essential oil. Int. J. Biol. Macromol. 2018, 114, 1094–1101. [Google Scholar] [CrossRef]
- Madigan, M.T.; Martinko, J.M.; Bender, K.S.; Buckley, D.H.; Stahl, D.A. Microbiologia de Brock, 14th ed.; Artmed: Porto Alegre, Brasil, 2016. [Google Scholar]
- Tongnuanchan, P.; Benjakul, S. Essential oils: Extraction, bioactivities, and their Uses for food preservation. J. Food Sci. 2014, 79, R1231–R1249. [Google Scholar] [CrossRef]
- Pacheco, T.; Barata, L.E.S.; Duarte, M.C.T. Antimicrobial activity of copaiba (Copaifera spp.) balsams. Rev. Bras. Plantas Med. 2006, 8, 123–124. [Google Scholar]
- Goren, A.C.; Piozzi, F.; Akcicek, E.; Kili, T.; Ariki, S.; Moziolu, E.; Setzer, W.N. Essential oil composition of twenty-two Stachys species (mountain tea) and their biological activities. Phytochem. Lett. 2011, 4, 448–453. [Google Scholar] [CrossRef]
- Dahham, S.S.; Tabana, Y.M.; Iqbal, M.A.; Ahamed, M.B.K.; Ezzat, M.O.; Majid, A.S.A.; Majid, A.M.S.A. The anticancer, antioxidant and antimicrobial properties of the sesquiterpene β-caryophyllene from the essential oil of Aquilaria crassna. Molecules 2015, 20, 11808–11829. [Google Scholar] [CrossRef] [PubMed]
- Santos, A.O.; Ueda-Nakamura, T.; Dias Filho, B.P.; Veiga, V.F.; Pinto, A.C.; Nakamura, C.V. Antimicrobial activity of Brazilian copaiba oils obtained from different species of the Copaifera genus. Mem. Inst. Oswaldo Cruz 2008, 103, 277–281. [Google Scholar] [CrossRef] [PubMed]
- Mali, S.; Grossmann, M.V.E.; García, M.A.; Martino, M.N.; Zaritzky, N.E. Barrier, mechanical and optical properties of plasticized yam starch films. Carbohydr. Polym. 2004, 56, 129–135. [Google Scholar] [CrossRef]
- Slavutsky, A.M.; Bertuzzi, M.A. Improvement of water barrier properties of starch films by lipid nanolamination. Food Packag. Shelf Life 2016, 7, 41–46. [Google Scholar] [CrossRef]
- Atarés, L.; Bonilla, J.; Chiralt, A. Characterization of sodium caseinate-based edible films incorporated with cinnamon or ginger essential oils. J. Food Eng. 2010, 100, 678–687. [Google Scholar] [CrossRef]
- Acosta, S.; Chiralt, A.; Santamarina, P.; Rosello, J.; González-Martínez, C.; Cháfer, M. Antifungal films based on starch-gelatin blend, containing essential oils. Food Hydrocoll. 2016, 61, 233–240. [Google Scholar] [CrossRef]
- Martínez-Ortiz, M.A.; Vargas-Torres, A.; Román-Gutiérrez, A.D.; Chavarría-Hernández, N.; Zamudio-Flores, P.B.; Meza-Nieto, M.; Palma-Rodríguez, H.M. Partial characterization of chayotextle starch-based films added with ascorbic acid encapsulated in resistant starch. Int. J. Biol. Macromol. 2017, 98, 341–347. [Google Scholar] [CrossRef]
- Moraes Crizel, T.; de Oliveira Rios, A.; Alves, V.D.; Bandarra, N.; Moldão-Martins, M.; Hickmann Flôres, S. Biodegradable films based on gelatin and papaya peel microparticles with antioxidant properties. Food Bioprocess Technol. 2018, 11, 536–550. [Google Scholar] [CrossRef]
- Ghasemlou, M.; Aliheidari, N.; Fahmi, R.; Shojaee-Aliabadi, S.; Keshavarz, B.; Cran, M.J.; Khaksar, R. Physical, mechanical and barrier properties of corn starch films incorporated with plant essential oils. Carbohydr. Polym. 2013, 98, 1117–1126. [Google Scholar] [CrossRef] [PubMed] [Green Version]
- Al-Hassan, A.A.; Norziah, M.H. Starch–gelatin edible films: Water vapor permeability and mechanical properties as affected by plasticizers. Food Hydrocoll. 2012, 26, 108–117. [Google Scholar] [CrossRef]
- Šuput, D.; Lazić, V.; Pezo, L.; Markov, S.; Vaštag, Ž.; Popović, L.; Radulović, A.; Ostojić, S.; Zlatanović, S.; Popović, S. Characterization of starch edible films with different essential oils addition. Polish J. Food Nutr. Sci. 2016, 66, 277–285. [Google Scholar] [CrossRef]
- Guerrero, P.; Stefani, P.M.; Ruseckaite, R.A.; De La Caba, K. Functional properties of films based on soy protein isolate and gelatin processed by compression molding. J. Food Eng. 2011, 105, 65–72. [Google Scholar] [CrossRef]
- Sartori, T.; Menegalli, F.C. Development and characterization of unripe banana starch films incorporated with solid lipid microparticles containing ascorbic acid. Food Hydrocoll. 2016, 55, 210–219. [Google Scholar] [CrossRef]
- Dammak, I.; Bittante, A.M.Q.B.; Lourenço, R.V.; do Amaral Sobral, P.J. Properties of gelatin-based films incorporated with chitosan-coated microparticles charged with rutin. Int. J. Biol. Macromol. 2017, 101, 643–652. [Google Scholar] [CrossRef]
- Fakhouri, F.M.; Batista, J.A.; Grosso, C.R.F. Desenvolvimento e caracterização de fimes comestiveis de gelatina, triacetina e ácidos graxos. Braz. J. Food Technol. 2003, 6, 301–308. [Google Scholar]
- Tumwesigye, K.S.; Oliveira, J.C.; Sousa-Gallagher, M.J. New sustainable approach to reduce cassava borne environmental waste and develop biodegradable materials for food packaging applications. Food Packag. Shelf Life 2016, 7, 8–19. [Google Scholar] [CrossRef]
- Bonilla, J.; Talón, E.; Atarés, L.; Vargas, M.; Chiralt, A. Effect of the incorporation of antioxidants on physicochemical and antioxidant properties of wheat starch-chitosan films. J. Food Eng. 2013, 118, 271–278. [Google Scholar] [CrossRef]
- Pelissari, F.M.; Grossmann, M.V.E.; Yamashita, F.; Pined, E.A.G. Antimicrobial, mechanical, and barrier properties of cassava starch-chitosan films incorporated with oregano essential oil. J. Agric. Food Chem. 2009, 57, 7499–7504. [Google Scholar] [CrossRef]
- Wang, Y.; Zhang, R.; Ahmed, S.; Qin, W.; Liu, Y. Preparation and characterization of corn starch bio-active edible packaging films based on zein incorporated with orange-peel oil. Antioxidants 2019, 8, 391. [Google Scholar] [CrossRef] [PubMed] [Green Version]
- Dashipour, A.; Razavilar, V.; Hosseini, H.; Shojaee-Aliabadi, S.; German, J.B.; Ghanati, K.; Khakpour, M.; Khaksar, R. Antioxidant and antimicrobial carboxymethyl cellulose films containing Zataria multiflora essential oil. Int. J. Biol. Macromol. 2015, 72, 606–613. [Google Scholar] [CrossRef] [PubMed]
- Shojaee-Aliabadi, S.; Hosseini, H.; Mohammadifar, M.A.; Mohammadi, A.; Ghasemlou, M.; Ojagh, S.M.; Hosseini, S.M.; Khaksar, R. Characterization of antioxidant-antimicrobial κ-carrageenan films containing Satureja hortensis essential oil. Int. J. Biol. Macromol. 2013, 52, 116–124. [Google Scholar] [CrossRef] [PubMed]
- Bertuzzi, M.A.; Castro Vidaurre, E.F.; Armada, M.; Gottifredi, J.C. Water vapor permeability of edible starch based films. J. Food Eng. 2007, 80, 972–978. [Google Scholar] [CrossRef]
- Ojagh, S.M.; Rezaei, M.; Razavi, S.H.; Hosseini, S.M.H. Development and evaluation of a novel biodegradable film made from chitosan and cinnamon essential oil with low affinity toward water. Food Chem. 2010, 122, 161–166. [Google Scholar] [CrossRef]
- Matiacevich, S.; Riquelme, N.; Herrera, M.L. Conditions to prolonged release of microencapsulated carvacrol on alginate films as affected by emulsifier type and PH. Int. J. Polym. Sci. 2015, 2015. [Google Scholar] [CrossRef] [Green Version]
- Xu, Y.X.; Kim, K.M.; Hanna, M.A.; Nag, D. Chitosan-starch composite film: Preparation and characterization. Ind. Crops Prod. 2005, 21, 185–192. [Google Scholar] [CrossRef]
- Lima, B.N.B.; Cabral, T.B.; Neto, R.P.C.; Tavares, M.I.B.; Pierucci, A.P.T. Estudo do amido de farinhas comerciais comestíveis. Polimeros 2012, 22, 486–490. [Google Scholar] [CrossRef] [Green Version]
- McMurry, J. Química Orgânica, 3rd ed.; Learning C: São Paulo, Brasil, 2016. [Google Scholar]
- Drusch, S.; Schwarz, K. Microencapsulation properties of two different types of n-octenylsuccinate-derivatised starch. Eur. Food Res. Technol. 2006, 222, 155–164. [Google Scholar] [CrossRef]
- Castro-Rosas, J.; Ferreira-Grosso, C.R.; Gómez-Aldapa, C.A.; Rangel-Vargas, E.; Rodríguez-Marín, M.L.; Guzmán-Ortiz, F.A.; Falfan-Cortes, R.N. Recent advances in microencapsulation of natural sources of antimicrobial compounds used in food—A review. Food Res. Int. 2017, 102, 575–587. [Google Scholar] [CrossRef]
- Manaf, M.A.; Subuki, I.; Jai, J.; Raslan, R.; Mustapa, A.N. Encapsulation of volatile citronella essential oil by coacervation: Efficiency and release study. IOP Conf. Ser. Mater. Sci. Eng. 2018, 358. [Google Scholar] [CrossRef]

| RT (min) | CI | LI | Compound | Content (%) |
|---|---|---|---|---|
| 23.370 | 1333 | 1335 | δ-Elemene | 0.42 |
| 24.121 | 1350 | 1350 | α-Longipinene | 0.73 |
| 25.034 | 1372 | 1374 | α-Copaene | 5.01 |
| 25.697 | 1389 | 1389 | β-Cubenene | 1.79 |
| 25.975 | 1394 | 1398 | Cyperene | 0.36 |
| 26.979 | 1408 | 1408 | β-Caryophyllene | 48.29 |
| 27.210 | 1424 | 1430 | β-Copaene | 0.11 |
| 27.428 | 1430 | 1432 | trans-α-Bergamotene | 0.96 |
| 27.596 | 1437 | 1437 | α-Guaiene | 11.58 |
| 27.820 | 1439 | 1440 | cis-β-Farnesene | 0.53 |
| 28.001 | 1444 | 1445 | epi-β-Santalene | 0.21 |
| 28.248 | 1450 | 1452 | α-Humulene | 0.77 |
| 28.500 | 1456 | 1458 | allo-Aromadendrene | 4.56 |
| 28.845 | 1464 | 1464 | 9-epi-Caryophyllene | 0.02 |
| 29.042 | 1469 | 1469 | β-Acoradiene | 0.23 |
| 29.333 | 1476 | 1478 | γ-Muurolene | 2.62 |
| 29.502 | 1481 | 1483 | α-Amorphene | 4.83 |
| 29.745 | 1487 | 1484 | Germacrene D | 1.10 |
| 30.110 | 1496 | 1496 | Viridiflorene | 0.40 |
| 30.235 | 1499 | 1502 | β-Guaiene | 1.08 |
| 30.339 | 1506 | 1505 | β-Bisabolene | 5.27 |
| 30.9 61 | 1510 | 1513 | γ-Cadinene | 0.64 |
| 31.057 | 1520 | 1522 | δ-Cadinene | 3.50 |
| 31.570 | 1533 | 1537 | α-Cadinene | 0.10 |
| 31.617 | 1532 | 1532 | γ-Cuprenene | 2.60 |
| 32.295 | 1552 | 1559 | Germacrene B | 0.76 |
| 35.314 | 1640 | 1640 | epi-α-Muurolol | 0.30 |
| 35.648 | 1645 | 1645 | Cubenol | 0.63 |
| 35.932 | 1649 | 1649 | β-Eudesmol | 0.39 |
| 36.191 | 1652 | 952 | α-Cadinol | 0.31 |
| Concentration (%) | B. subtilis | S. aureus |
|---|---|---|
| 3 | 7.75 ± 0.07 d | 6.86 ± 0.06 c |
| 6 | 8.86 ± 0.07 cd | 7.00 ± 0.09 c |
| 12 | 9.88 ± 0.12 c | 8.43 ± 0.28 bc |
| 25 | 9.88 ± 0.04 c | 9.50 ± 0.14 bc |
| 50 | 12.75 ± 0.09 b | 11.13 ± 0.27 b |
| 100 | 15.00 ± 0.23 a | 15.00 ± 0.18 a |
| Positive control | 27.00 ± 0.00 | 20.00 ± 0.00 |
| Negative control | Nd | Nd |
| Analyzes | F1 | F2 | F3 |
|---|---|---|---|
| Luminosity (L*) | 90.84 ± 0.56 ª | 90.49 ± 0.56 ab | 90.13 ± 0.24 b |
| Transparency (%) | 6.18 ± 0.45 b | 4.88 ± 0.30 c | 8.89 ± 0.23 a |
| Thickness (mm) | 0.074 ± 0.002 a | 0.079 ± 0.001 a | 0.077 ± 0.002 a |
| Stress at break (MPa) | 3.46 ± 0.12 a | 2.41 ± 0.33 b | 3.42 ± 0.32 a |
| Elongation (%) | 16.44 ± 1.00 b | 15.47 ± 2.53 b | 20.05 ± 2.16 a |
| Moisture (%) | 21.57 ± 2.93 a | 19.65 ± 0.99 a | 13.93 ± 2.79 b |
| Solubility in water (%) | 20.00 ± 0.65 a | 15.89 ± 1.07 b | 16.87 ± 0.68 b |
| Contact angle (°) | 47.19 ± 4.89 c | 92.45 ± 6.67 a | 81.78 ± 2.79 b |
| Formulation | B. subtilis | S. aureus |
|---|---|---|
| F1 | Nd | Nd |
| F2 | 9.75 ± 0.07 | Nd |
| F3 | 11.38 ± 0.11 | 8.80 ± 0.04 |
| 12% of copaiba oil * | 9.88 ± 0.12 | 8.43 ± 0.28 |
Publisher’s Note: MDPI stays neutral with regard to jurisdictional claims in published maps and institutional affiliations. |
© 2020 by the authors. Licensee MDPI, Basel, Switzerland. This article is an open access article distributed under the terms and conditions of the Creative Commons Attribution (CC BY) license (http://creativecommons.org/licenses/by/4.0/).
Share and Cite
Rodrigues, G.d.M.; Filgueiras, C.T.; Garcia, V.A.d.S.; Carvalho, R.A.d.; Velasco, J.I.; Fakhouri, F.M. Antimicrobial Activity and GC-MS Profile of Copaiba Oil for Incorporation into Xanthosoma mafaffa Schott Starch-Based Films. Polymers 2020, 12, 2883. https://doi.org/10.3390/polym12122883
Rodrigues GdM, Filgueiras CT, Garcia VAdS, Carvalho RAd, Velasco JI, Fakhouri FM. Antimicrobial Activity and GC-MS Profile of Copaiba Oil for Incorporation into Xanthosoma mafaffa Schott Starch-Based Films. Polymers. 2020; 12(12):2883. https://doi.org/10.3390/polym12122883
Chicago/Turabian StyleRodrigues, Giovana de Menezes, Cristina Tostes Filgueiras, Vitor Augusto dos Santos Garcia, Rosemary Aparecida de Carvalho, José Ignacio Velasco, and Farayde Matta Fakhouri. 2020. "Antimicrobial Activity and GC-MS Profile of Copaiba Oil for Incorporation into Xanthosoma mafaffa Schott Starch-Based Films" Polymers 12, no. 12: 2883. https://doi.org/10.3390/polym12122883
APA StyleRodrigues, G. d. M., Filgueiras, C. T., Garcia, V. A. d. S., Carvalho, R. A. d., Velasco, J. I., & Fakhouri, F. M. (2020). Antimicrobial Activity and GC-MS Profile of Copaiba Oil for Incorporation into Xanthosoma mafaffa Schott Starch-Based Films. Polymers, 12(12), 2883. https://doi.org/10.3390/polym12122883









